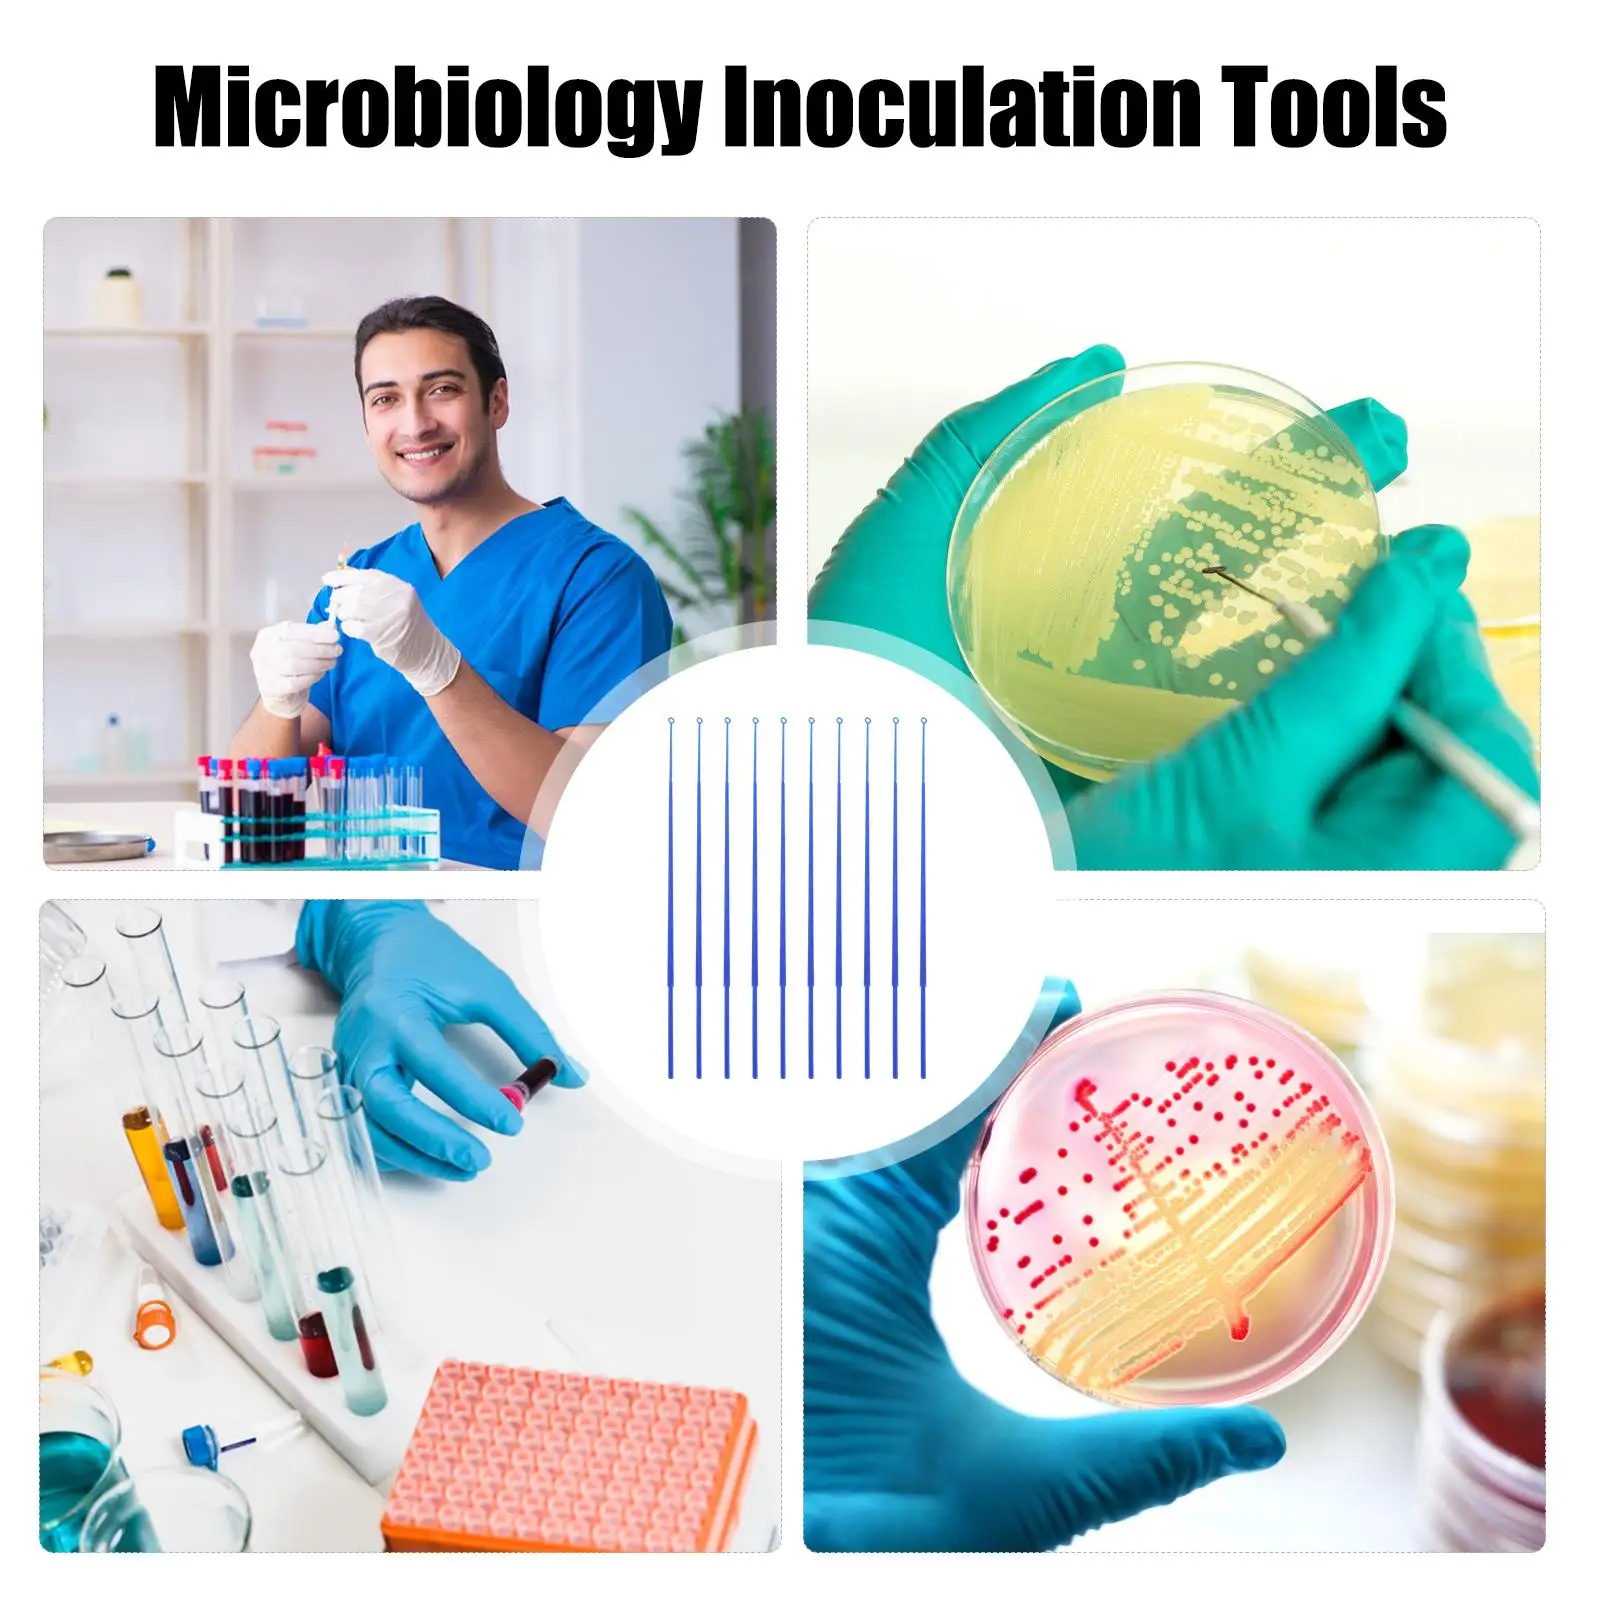
thumb

20 Pcs Inoculation Rods Microbiology Lab Tools 5ul Sampling Sticks Disposable Device Lightweight Heat Resistant Stable Test
Price history chart & currency exchange rate
Customers also viewed

$11.92
Woodworking Men Lumberjack Gifts Arborist Chainsaw T-Shirt blanks sublime mens clothes
aliexpress.ru
$58.54
Набор из 5 держателей настенная полка для ванной комнаты хранилище для всякой всячины 35,5x12x5,5 см Органайзер прозрачный клейкий
aliexpress.ru
$8.82
Hair Comb for Detangling - Wide Tooth Wood Comb for Curly Hair - No Static Natural Wooden Sandalwood Comb
aliexpress.com
$11.14
Hot Compress Eye Massager Pen Smart Disinfection LED Eye Wrinkle Removals Lip Skin Tighten Lip Lines Eye Massager AntiAging A9L5
aliexpress.com
$26.80
JONSBO CR-1000 PRO 6 Heatpipe for Intel 115X 1200 AM4 CPU Cooler Quiet PWM 4PIN Fan Desktop PC Cooler
aliexpress.com
$11.81
2022 Fashion Vintage Anime T Shirt Cobra Kai Double Sided Print T-Shirt Karate Strike First Strike Hard No Mercy Tee Shirt Men's
aliexpress.com
$7.70
100Pcs/Set Food Grade Ice Pop Bags Disposable Plastic Popsicle Bags Freeze Treat Storage Transparent Ice Popsicle Mold Bag
aliexpress.com
$24.70
Motorcycle Bag Right Crash Bar Saddlebag Guard Bag Water Bottle Holder For Harley Touring Road King Electra Road Glide 1993-up
aliexpress.com
$1.85
XW92126,22mm 12 color style,Christmas snowflake Series Printed grosgrain ribbon,DIY handmade materials,headwear accessories
aliexpress.com
$173.86
Original Samsung Galaxy S6 Edge G925F Cell Phone 5.1 inch curved screen Octa Core 32GB ROM 4G unlocked ,Free DHL-EMS shipping
aliexpress.com
$11.23
oklahoma''city''thunder''bobble hats baseball ball caps 2019-23 fashion designer bucket hat chunky knit faux p, Blue;gray
dhgate.com
$2.64
Silicone Case Protector Sleeve Wireless Earbuds Protect Shell Earphone Cover Soft Colourful Earbuds Protective Cases Silicone
aliexpress.com
$7.34
chokers vintage multi-layer chain necklace for women trendy multilayered gold snake stars choker girls party neck jewelry, Golden;silver
dhgate.com
$20.19
Kitchen Under Sink Storage Rack Cabinet Expandable Shelf Stainless Steel Multi-Layer Pot Rack bathroom Floor Organizer shelves
aliexpress.com
$0.94
Picture Cards For Toddlers And Children Expand Knowledge Attractive Picture Durable Cards Reading Cards
aliexpress.com
$11.34
100pcs 6Size Car Accessory Mixed Auto Fastener Clip Body Push Retainer Pin Rivet Bumper Door Trim Panel Fastener Kit for Mazda
aliexpress.com
$5.27
Новая куртка из джинсовой ткани с Материал повязки для волос для женщин и девочек творческая цепочка толстой подошве обмотки повязки на гол...
aliexpress.com
$61.97
dress shoes autumn leopard women high heels 6-10cm elegant office pumps animal print pointed toe luxury singles, Black
dhgate.com
$0.40
4.5mm In-ear Bowl Type Silicone Earphones Ear Caps Soft Headphone Cover Silicone Earplugs Headset Cover ,silicone Earphones
aliexpress.com
$0.78
Bear Bat Prick Beads Edible Pearl SUGAR BALL Fondant DIY Cake Baking Chocolate Decoration Sugar Candy Fimo Clay
aliexpress.com
$9.39
ALLNeon 90s Retro Five-pointed Star Halter Tank Top Y2K Aesthetics Summer Bandage Slim Camis E-Girl Grunge Sleeveless Crop Vest
aliexpress.com
$5.73
10 pieces/pack Avengers Orange Sun UV transfer stickers Crystal label Cup stickers customized four inches
aliexpress.com$17.95
Заживляющий, питательный бальзам для губ Dr. Ceuracle Vegan Kombucha Tea Lip Balm 3,7g
patchandgo.ru
$62.87
Subculture Lace Stitching Long Sleeve Dress Female Halloween Gothic Style Lace Dress Women's Embroidery Wedding Dress
aliexpress.com
$93.03
Latest Pink Mother Of The Bride Dresses Chiffon Lace Appliques Pleat Long Sleeve A-Line Floor Length Party Customized Dress
aliexpress.com
$26.93
New Large Unisex Barefoot Fitness Footbed Lightweight Sports Mens Hard Pull Deep Squat Trainers Women's Wide Toe Casual Shoes Ne
aliexpress.com
$32.90
2025 Весна Мужская Цветочная Вышитая Рубашка Мужская Мода Повседневная Свободная Рубашка С Длинным Рукавом Мягкие Топы Унисекс Мужская Черная Белая Блузка 4XL белый
joom.com